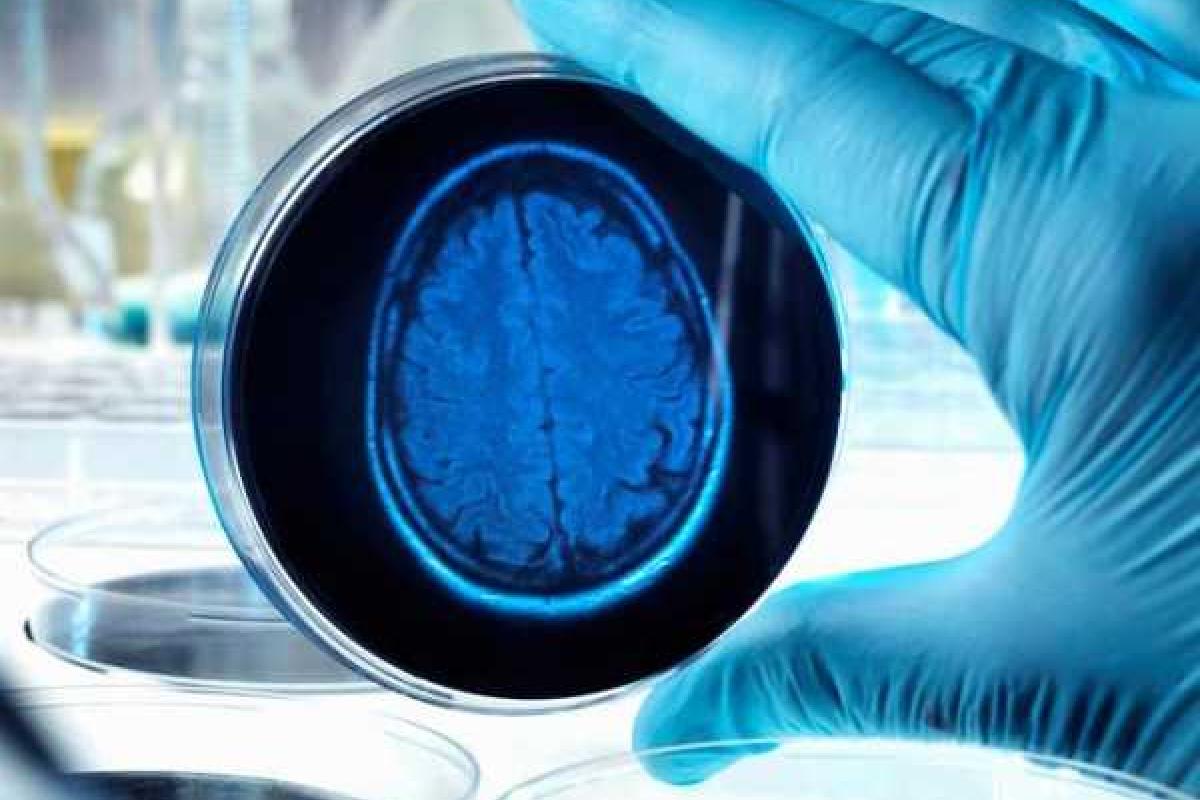
Американские ученые вырастили в лаборатории копию человеческого мозга Американские ученые вырастили в лаборатории копию человеческого мозга

Исследователи Университета Огайо рассказали, что им удалось вырастить почти полную копию человеческого мозга. Сообщение об этом было опубликовано на сайте учреждения.
Руководитель группы, проводившей эксперимент, профессор Рене Ананд заявил, что выращенный его командой образец соответствует мозгу пятинедельного эмбриона. В нем воспроизведены 99% генов, присутствующих в обычном человеческом мозге, и представлены все основные отделы.
Как утверждает Ананд, эта самая точная на сегодняшний день биологическая модель мозга, в предыдущие разы получалось скопировать только отдельные аспекты мозга.
Модель выращивали около 12 недель. Основой образца стали взрослые клетки кожи, перепрограммированные в индуцированные стволовые клетки, которые могут образовать любую ткань в организме.
По мнению ученого, искусственный мозг необходим для изучения причин возникновения различных заболеваний нервной системы и проверки эффективности лекарственных средств.
У искусственного мозга отсутствует система кровеносных сосудов, в него поступают сенсорные стимулы и мыслительный процесс в нем не происходит, что, по мнению ученых, исключает возможные этические проблемы.
Ученые пока не публикуют полный отчет об исследовании, отметив, что сделают это после получения им патента на технологию.
Рене Ананд является сооснователем стартапа NeurXstem, посвященного коммерциализации придуманного им метода по производству копий мозга.
















